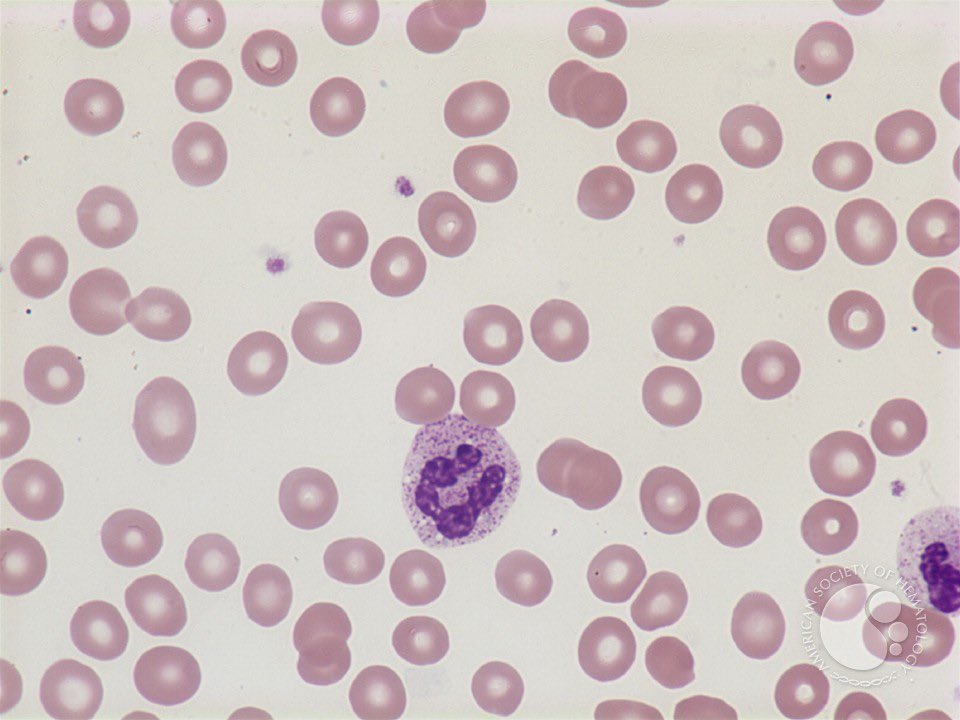

اولا :
الأنيميا هي حالة طبية تحدث عندما يكون لديك نقص في عدد خلايا الدم الحمراء أو نقص في كمية الهيموغلوبين الموجودة في هذه الخلايا. الهيموغلوبين هو بروتين يحمل الأكسجين في جسمك ويساعد في توصيله إلى جميع الأنسجة والأعضاء.
الأنيميا هي حالة طبية تحدث عندما يكون لديك نقص في عدد خلايا الدم الحمراء أو نقص في كمية الهيموغلوبين الموجودة في هذه الخلايا. الهيموغلوبين هو بروتين يحمل الأكسجين في جسمك ويساعد في توصيله إلى جميع الأنسجة والأعضاء.
الآن نحدد نوعها
ننظر الى نسبة :
■ ال MCV و نلاحظ هل هي طبيعية أو أقل من الطبيعي أو أعلى من الطبيعي؟
ننظر الى نسبة :
■ ال MCV و نلاحظ هل هي طبيعية أو أقل من الطبيعي أو أعلى من الطبيعي؟
ننظر إلى
• الRDW الموجودة في التحليل والذي هو ( Red Cell Distribution Width )
و الذي يعتبر مقياس لمعدل الإختلاف بين حجم الخلايا الحمراء لنفس الحالة. (بمعنى أنه لما يرتفع يعني الاختلاف في شكل وحجم الخلايا كبير،
و لما يقل يعني الخلايا تقريبا متشابهة )
• الRDW الموجودة في التحليل والذي هو ( Red Cell Distribution Width )
و الذي يعتبر مقياس لمعدل الإختلاف بين حجم الخلايا الحمراء لنفس الحالة. (بمعنى أنه لما يرتفع يعني الاختلاف في شكل وحجم الخلايا كبير،
و لما يقل يعني الخلايا تقريبا متشابهة )
في حالات الـ Thalassemia تكون الخلايا متشابهة جدا أي إن الRDW يقل فيها لأنها نفس الحجم .
بينما في حالة IDA تكون فيها الخلايا غير متشابهة ومختلفة الشكل والحجم anisopoikilocytosis وبالتالي يرتفع الRDW فيها
بينما في حالة IDA تكون فيها الخلايا غير متشابهة ومختلفة الشكل والحجم anisopoikilocytosis وبالتالي يرتفع الRDW فيها
يعني باختصار ⏳
لما يكون RDW قليل يعني الحالة Thalassemia ،
ولما يكون عالي يعني نقص حديد IDA.
ولو شكينا إنها Thalassemia ! نعمل hemoglobin electrophoresis للتأكيد
لما يكون RDW قليل يعني الحالة Thalassemia ،
ولما يكون عالي يعني نقص حديد IDA.
ولو شكينا إنها Thalassemia ! نعمل hemoglobin electrophoresis للتأكيد
نلاحظ WBC و PLT :
لو كانوا طبيعين يعني حالة Hemolytic Anemia ،
ونتاكد ايضا بإن الخلايا الشبكية تكون عالية.
لو كانوا طبيعين يعني حالة Hemolytic Anemia ،
ونتاكد ايضا بإن الخلايا الشبكية تكون عالية.
ولو WBC و PLT كانوا منخفضين يعني المريض عنده panecytopenia .
وما دام توجد panecytopenia يعني سببها واحد من اثنين :
اما انخفاض في انتاج خلايا الدم يعني aplastic anemia
او تنتج طبيعي لكن توجد زيادة في تكسير الخلايا بسبب الطحال يعني Hypersplenism .
وما دام توجد panecytopenia يعني سببها واحد من اثنين :
اما انخفاض في انتاج خلايا الدم يعني aplastic anemia
او تنتج طبيعي لكن توجد زيادة في تكسير الخلايا بسبب الطحال يعني Hypersplenism .
اخيرااا …
علاج الأنيميا🩸:
يعتمد على السبب الأساسي للحالة. في بعض الحالات، يمكن تناول مكملات غذائية تحتوي على الحديد أو فيتامين ب12 أو حمض الفوليك. قد يحتاج بعض الأشخاص إلى تلقي علاج بالأدوية أو إجراء عملية جراحية في حالات خاصة.
علاج الأنيميا🩸:
يعتمد على السبب الأساسي للحالة. في بعض الحالات، يمكن تناول مكملات غذائية تحتوي على الحديد أو فيتامين ب12 أو حمض الفوليك. قد يحتاج بعض الأشخاص إلى تلقي علاج بالأدوية أو إجراء عملية جراحية في حالات خاصة.
جاري تحميل الاقتراحات...